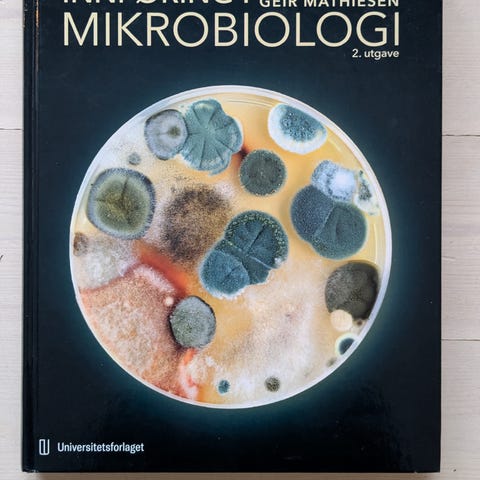
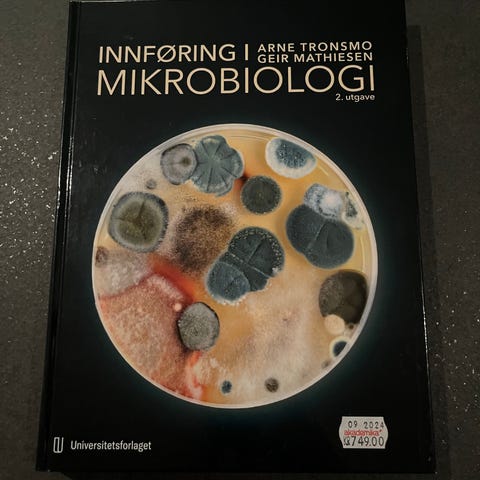

Fiks ferdig
Frakt fra 45 kr + Trygg betaling 40 kr
Varen sendes til deg, og du har 24 timer til å inspisere den før pengene overføres til selgeren.
Tilstand: Pent brukt - I god stand
Emne: Biologi
Innføring i mikrobiologi av Arne Tronsmo
ISBN: 978-82-15-02592-6

Du må være logget inn for å se brukerprofiler og sende meldinger.
Logg innSist endret: 23.12.2025 kl. 13:08 ・ FINN-kode: 442970805